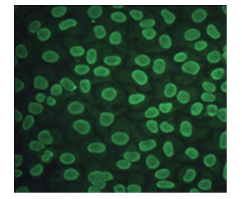

Description
Details
Description: Mouse monoclonal antibody to human cancer antigen 125 (CA125)
Purification: Protein G affinity purified
Product Type: Primary antibody
Target Protein: Human CA 125
Immunogen: Human CA 125 protein
Fusion Myeloma: Sp2/0-Ag14
Specificity: React with human CA 125
Reacitvity: Human, others not tested
Species Reacitvity: Not available
Host / Isotype: Mouse, IgG2a Kappa
Formulation: Lyophilized from a solution in 0.01M PBS, pH 7.2
Reconstitution: Double distilled water is recommended to reconstitute the antibody.
Storage: Store at -20oC
Research Area: Oncology
Background:
Cancer antigen 125 (CA125), also called mucin16, is a heterogeneous mixture of glycoproteins with a molecular weight range of 200-1000 kDa. Its C-end is attached to cell membrane. The extra-cellular region of the molecule can be released from cell surface by proteolytic cleavage. CA125 was found to be elevated in the blood of patients with advanced ovarian cancer. It is very useful for monitoring the effects of ovarian cancer therapy and is used for predicting the outcome of the patients after treatment.
Application:
1. Fluorescence flow cytometry: Above is the histogram of Hela cells stained with 10μg/mL anti-CA 125 mAb clone 15 and fluorescence-labelled secondary antibody. Black line represents the histogram of Hela cells stained with control antibody, mouse anti-TB 38Kd antigen mAb clone B12F8 (MO-I40021D).

2. Immunofluorescence: Staining of methanol-fixed Hela cells by Immuno-fluorescence: Anti-CA 125 mAb clone 15 was used at 10μg/mL.
3. ELISA: This antibody, when used at 0.5ng/mL or higher concentrations, can recognize ELISA plate wells coated with CA125 at 5 international unit per well.
References:
If research is published using this product, please inform Anogen in order to cite the reference on this datasheet. Anogen will provide one unit of product in the same category as gratitude.
Additional
Additional Information
| Product Specificity | mAb anti-CA 125, 15 |
|---|---|
| Application | IF, IHC, EIA |
| Size | 0.1 mg |